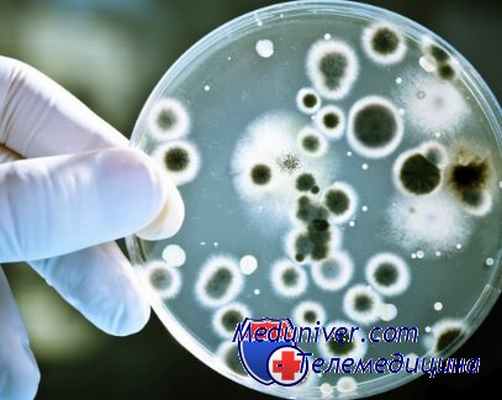
вирусный гепатит

Цитолиз при вирусном гепатите. Мезенхимально-воспалительный синдром при гепатите
Добавил пользователь Alex Обновлено: 12.12.2025
Болезни печени сопровождаются рядом лабораторных синдромов. При анализе результатов биохимического исследования у больных с заболеваниями печени целесообразно выделять четыре лабораторных синдрома, каждый из которых в известной степени соответствует определенным морфологическим и функциональным изменениям в органе: цитолитический синдром, мезенхимально-воспалительный синдром, холестатический синдром (синдом холестаза), синдром малой печеночно-клеточной недостаточности, Обычно в каждом конкретном случае заболевания имеет место сочетание нескольких биохимических синдромов.
Цитолитический синдром (синдром нарушения целостности гепатоцитов)
Цитолитический синдром встречается при вирусных, лекарственных, токсических гепатитах и других острых повреждениях печени, циррозе печени, хроническом активном гепатите, а также при быстро развивающейся или длительной обтурационной желтухе; морфологически для этого синдрома характерны ацидофильная и гидропическая дистрофия, некроз гепатоцитов с повреждением клеточных мембран и повышением их проницаемости.
Цитолитический синдром обусловлен:
нарушением проницаемости клеточных мембран
распадом мембранных структур
выходом в плазму ферментов
лабораторные признаки цитолитического синдрома:
•повышение активности ферментов в плазме крови
(АлАТ, АсАТ, ЛДГ и ее изофермент ЛДГ5, альдолаза и др.)
•гипербилирубинемия (преимущественно прямая реакция)
•повышение в сыворотке крови концентрации железа
коэффициент Де Ритиса
коэффицент определяется соотношением АсАТ/АлАТ - отражает степень тяжести поражения печени. В норме - 1,3-1,4. Повышение коэффициента Де Ритиса более 1,4 (преимущественно за счет АсАТ) наблюдается при тяжелых поражениях печени с разрушением большей части печеночной клетки (хронический активный гепатит с высокой степенью активности, цирроз печени, опухоль); при острых процессах, разрушающих мембрану клетки и не затрагивающих глубинные структуры печеночной клетки, коэффициент Де Ритиса меньше 1,2.
Синдром малой печеночно-клеточной недостаточности (без печеночной энцефалопатии)
Синдром малой печеночно-клеточной недостаточности - это группа биохимических признаков, свидетельствующих о значительном снижении различных функций печени, в первую очередь синтетических. Синдром печеночно-клеточной недостаточности клинически характеризуется лихорадкой, снижением массы тела, желтухой, геморрагическим диатезом, внепеченочными знаками: «печеночный язык», «печеночные ладони», «сосудистые звездочки», изменение ногтей, оволосения, гинекомастия и др.; морфологически для этого синдрома характерны дистрофические изменения гепатоцитов, значительное уменьшение функциональной паренхимы печени вследствие изменений последней
лабораторные признаки синдрома малой печеночно-клеточной недостаточности:
•понижение активности холинэстеразы в плазме крови
•уменьшение содержания в сыворотке крови протромбина
•гипоальбуминемия и (реже) гипопротеинемия
•уменьшение содержания V и VII факторов свертывания крови
•уменьшение концентрации холестерина
•гипербилирубинемия (преимущественно за счет увеличения свободного билирубина)
•повышение в крови уровня трансаминаз (АсАТ, АлАТ)
•повышение в крови печеночно-специфических ферментов - фруктозо-1-фос-фатальдолазы, сорбитдегидрогеназы, орнитинкарбамилтранс-феразы и др.
Воспалительный синдром (мезенхимально-воспалительный синдром)
Свидетельствует об активности патологического процесса в печени, клинически характеризуется лихорадкой, артралгиями, лимфаденопатией, спленомегалией, васкулитами (кожа, легкие); морфологически данный синдром характеризуется активацией и пролиферацией лимфоидных и ретикулогистиоцитарных клеток, внутрипеченочной миграцией лейкоцитов, усилением фиброгенеза, формированием активных септ с некрозами вокруг них, васкулитами.
Воспалительный синдром обусловлен развитием в печени так называемого иммунного воспаления: сенсибилизацией иммунокомпетентной ткани, активацией ретикулогистиоцитарной системы, инфильтрацией портальных протоков и внутридольковой стромы.
Лабораторные признаки воспалительного синдрома
•повышение уровня γ-глобулинов сыворотки, нередко в сочетании с гипопротеинемией;
•изменение белково-осадочных проб (тимоловой, сулемовой);
•появление неспецифических маркеров воспаления - повышение СОЭ, увеличение серомукоида, появление С-реактивного белка и др.
•повышение уровня IgG, IgM, IgA (см. ниже)
•повышение в крови неспецифических антител - к ДНК, гладкомышечным волокнам, митохондриям, микросомам, печеночному липопротеиду; появление LE-клеток
•изменение количества и функциональной активности Т- и В-лимфоцитов и их субпопуляций - изменение реакции бластной трансформации лимфоцитов (БТЛ)
повышение концентрации IgM
характерно для первичного билиарного цирроза
повышение концентрации IgG
характерно для активного хронического гепатита
повышение концентрации IgA
характерно для алкогольного поражения печени
Синдром холестаза
Виды холестаза:
- внутрипеченочный (первичный) холестаз
Синдром холестаза обусловлен нарушением желчевыделительной функции гепатоцитов и поражением желчных канальцев (дисрегуляция собственно желчьсекретирующих механизмов гепатоцитов); проявляется ультраструктурными изменениями гепатоцита и гиперплазией гладкой цитоплазматической сети, изменением билиарного полюса гепатоцита, накоплением компонентов желчи в гепатоците
- внепеченочный (вторичный) холестаз
Синдром холестаза обусловен нарушением оттока желчи по печеночным и общему желчному протокам вследствие их обтурации -нарушением секреции желчи (развивается в случаях желчной гипертензии, которая в свою очередь связана с препятствием нормальному току желчи в желчевыводящих путях); происходит расширение междольковых желчных протоков, изменение их эпителия с накоплением в дальнейшем компонентов желчи в гепатоцитах и во всей билиарной системе; выявляется накопление желчи в желчных ходах
Клинические проявления холестатического синдрома:
Упорный кожный зуд, желтуха, пигментация кожи, ксантелазмы, потемнение мочи, посветление кала
Лабораторные признаки холестатического синдрома
•повышение активности щелочной фосфатазы, γ-глутамилтранспептидазы (ГГТП) и некоторых других экскреторных ферментов - лейцинаминопептидазы, 5-нуклеотидазы и др.
•гиперхолестеринемия, нередко в сочетании с повышением содержания фосфолипидов, β-липопротеидов, желчных кислот
•гипербилирубинемия (преимущественно за счет повышения концентрации прямого (конъюгированного) билирубина)
Цитолиз при вирусном гепатите. Мезенхимально-воспалительный синдром при гепатите
Цитолиз при вирусном гепатите. Мезенхимально-воспалительный синдром при гепатите
Заболевания различаются по типу возбудителя, механизмам повреждения печени, клинической картине и исходам. Данная группа болезней не включает вирусные гепатиты, развивающиеся в качестве синдромов при инфекциях, вызванных EBV, CMV, Herpesvirus, Yellow fever virus и др. (так называемые гепатиты-спутники).
Гепатотропность возбудителей вирусных гепатитов объясняет сходство основных клинических проявлений заболеваний, представленных в период разгара характерными клинико-биохимическими и патоморфологическими синдромами или их сочетаниями, несмотря на то, что инфекции вызваны разными вирусами и имеют существенные различия в патогенезе.
Основным синдромом поражения печени при гепатитах является цитолиз. Цитолиз — повышение проницаемости клеточных мембран, сопровождающееся нарушением внутриклеточного метаболизма. Происходит перераспределение биологически активных веществ — выход за пределы клетки печеночно-клеточных ферментов (АлАТ, ЛДГ5 и др.) и ионов калия, проникновение в клетку жидкости и ионов натрия, кальция (отек, набухание). Диффузный цитолиз и дистрофия сопровождаются нарушениями функции печени (детоксической, белково-синтетической, пищеварительной, нарушениями пигментного обмена и др.).
Клиническая выраженность симптомов зависит от тяжести поражения и реализации мощной компенсаторной возможности органа. Типичными проявлениями диффузного цитолиза и дистрофии гепатоцитов является синдром интоксикации — астения, повышенная утомляемость, недомогание, сонливость, разбитость, головокружение. Интоксикация определяется метаболическими изменениями, обусловленными нарушением детоксической функции печени (аутоинтоксикация), обычно не сопровождается лихорадкой. С цитолизом связано нарушение пигментного обмена, что проявляется желтухой южных покровов и слизистых оболочек, потемнением мочи и ахолией кала.
Типичным признаком гепатита является увеличение размеров печени, плотновато-эластическая консистенция органа, восстановление размеров по мере обратного развития заболевания. Диспепсические жалобы обусловлены нарушением функции желчеобразования и выделения желчи, вовлечением в процесс гастродуоденальной и панкреатической зоны. Характерно снижение аппетита, тошнота, возможна рвота, ощущение дискомфорта и/или болей в эпигастральной области и правом подреберье. При тяжелой форме заболевания проявлением нарушения белково-синтетической функции печени становится геморрагический синдром, обусловленный дефицитом факторов свертывания, синтезируемых печенью (протромбин, проакцелерин, проконвертин), а также дефектами противосвертывающей системы крови.
Мезенхимально-воспалительный синдром, выраженный в большей или меньшей степени, свойственен большинству заболеваний печени и связан с реакцией ретикулоэндотелиальной системы на антигенную стимуляцию. Мезенхимально-воспалительный синдром приобретает важное значение в развитии и прогрессировании хронических гепатитов, с ним связан активный фиброгенез, формирование цирроза, портальная гипертензия и др. Лабораторными признаками мезенхимально-воспалительного синдрома являются повышение уровня глобулинов и выраженная гипергаммаглобулинемия, увеличение содержания иммуноглобулинов всех классов, изменение количества лейкоцитов в периферической крови и увеличение СОЭ, снижение сулемового титра и повышение тимоловой пробы.
Информация на сайте подлежит консультации лечащим врачом и не заменяет очной консультации с ним.
См. подробнее в пользовательском соглашении.
Учебный материал:
Основные вопросы темы изложены в учебнике. При подготовке к занятию необходимо обратить внимание на то, что вирусные гепатиты представляют собой группу совершенно самостоятельных вирусных заболеваний, несвязанных между собой и независимых (за исключением гепатотропных инфекций В и D) одна от другой. Все они вызываются несходными и неродственными вирусами. Вирус гепатита В имеет сложное антигенное строение. Необходимо обратить внимание на различие механизмов передачи вирусов: для гепатитов А и Е – это фекально-оральный механизм, для остальных гепатитов – парентеральный. Механизм развития цитолиза при гепатитах разной этиологии имеет отличия: при гепатитах А; Е; Д цитолиз развивается в результате прямого цитопатического действия вируса на гепатоцит, при гепатитах В и С – носит иммуноопосредственный характер.
При подготовке к занятию необходимо уяснить, что в течении острого вирусного гепатита выделяют следующие периоды: инкубационный, преджелтушный, желтушный и период реконвалесценции, но в зависимости от этиологии они имеют свои особенности течения. Обратить внимание на современную классификацию вирусных гепатитов, критерии тяжести как клинические: степень интоксикации, выраженности желтухи, гепатомегалии, геморрагического синдрома, так и лабораторные: уровень билирубина, значение ПТИ, сулемовой пробы. Обратить внимание на течение типичной (желтушной) формы гепатита, а также знать отличия в клиническом течении безжелтушных, стертых и субклинических форм, критерии их диагностики.
Основными синдромами, развивающимися при гепатитах независимо от этиологии, являются:
СИНДРОМ ЦИТОЛИЗА – основной синдром гепатита связан с повреждением печеночной клетки и повышением проницаемости клеточных мембран. Он может быть обусловлен прямым цитопатическим действием вируса, когда клетка повреждается в процессе репликации вируса (как при ВГА; ВГД) или явиться результатом иммуноопосредованных механизмов (как при ВГВ), при этом происходит дезорганизация структуры клеточных мембран, что ведет к повышению проницаемости, как мембран гепатоцитов, так и внутриклеточных органелл. Нарушаются все виды обмена: белковый, углеводный, жировой, пигментный и др. Клинически синдром цитолиза проявляется интоксикацией (слабость, головная боль, температура, тошнота, рвота, потливость, плохой аппетит, нарушение психики, сна), желтухой, геморрагическим синдромом (носовые кровотечения, петехиальная сыпь, кровоточивость). Лабораторно: определяются рост билирубина (тяжесть цитолиза, определяет больше рост непрямой фракции), повышение АЛТ, снижение альбумина, протромбина.
МЕЗЕНХИМАЛЬНО-ВОСПАЛИТЕЛЬНЫЙ СИНДРОМ связан с поражением купферовских клеток, скоплением серозного экссудата в пространстве Диссе, пролиферацией лимфоидных клеток по портальным трактам. Наблюдается при всех клинически выраженных гепатитах, основные проявления – гепатомегалия, тяжесть или боль в правом подреберье. Лабораторно: характеризуется увеличением тимоловой пробы и снижением сулемовой, гипергаммаглобулинемией, уробилинурией.
СИНДРОМ ХОЛЕСТАЗА – наблюдается лишь при желтушных формах. Связан с нарушением реологии и оттока желчи. Проявления холестаза могут быть незначительными или выраженными при развитии холестатических форм болезни. Клинически проявляется желтухой с зудом кожи, нарушением цвета мочи и кала. Лабораторно: рост общего билирубина преимущественно за счет прямой фракции, увеличение щелочной фосфатазы, холестерина; в моче – появление желчных пигментов и исчезновение уробилина, снижение или отсутствие стеркобилина в кале.
Вирусный гепатит А (ГА) — острая энтеровирусная циклическая инфекция с преимущественно фекально-оральным механизмом заражения.
Этиология. Возбудитель — вирус гепатита А (ВГА) — РНК-содержащий энтеровирус 72 типа, относящийся к семейству пикорнавирусов. ВГА устойчив к окружающей среде: при комнатной температуре может сохраняться в течение нескольких недель, а при 4°С — несколько месяцев. Однако его можно инак-тивировать кипячением в течение 5 минут, автоклавированием, ультрафиолетовым облучением или воздействием дезинфектантов. Эпидемиология. Источником инфекции чаще всего являются больные с бессимптомной (субклинический и инаппарантный варианты) формой, безжелтушным и стертым течением инфекции или больные, находящиеся в инкубационном, продромальном периодах и начальной фазе периода разгара болезни, в фекалиях которых обнаруживаются ВГА (HAV).
Ведущий механизм заражения ГА — фекально-оральный, реализуемый водным, пищевым и контактно-бытовым путями передачи. Существует возможность реализации данного механизма и половым путем при орально-генитальных контактах.
Восприимчивость к ГА всеобщая. Наиболее часто заболевание регистрируется у детей старше 1 года (особенно в возрасте 3-12 лет в организованных коллективах) и у молодых лиц (20-29 лет). Дети до 1 года малочувствительны к заражению ввиду сохранения у них пассивного иммунитета, переданного от матери.
ГА свойственно сезонное повышение заболеваемости в летне-осенний период.
Патогенез. ГА — острая циклическая инфекция, характеризующаяся четкой сменой периодов.
После заражения ВГА из кишечника проникает в кровь и далее в печень, где после фиксации к рецепторам гепатоцитов проникает внутрь клеток. На стадии первичной репликации отчетливых повреждений гепатоцитов не обнаруживается. Новые поколения вируса выделяются в желчные канальцы, далее поступают в кишечник и выделяются с фекалиями во внешнюю среду. Часть вирусных частиц проникает в кровь, обусловливая развитие интоксикационной симптоматики продромального периода. Повреждения гепатоцитов, возникающие в ходе дальнейшего течения ГА, обусловлены не репликацией вируса, а иммуноопосредованным цитолизом. В периоде разгара ГА морфологическое исследование позволяет выявить воспалительные и некробиотические процессы, происходящие преимущественно в перипортальной зоне печеночных долек и портальных трактах.
Острый ГА может протекать в клинически проявляющихся вариантах (желтушных и безжелтушных) и инаппарантном (субклиническом), при котором клинические симптомы полностью отсутствуют. Инкубационный период составляет от 2 до 6 недель, в среднем 20-30 дней.
Преджелтушный (продромальный) период. Продром-короткий, острый, его длительность составляет от 3 до 7 дней. Наиболее характерными симптомами являются повышение температуры тела, чаще выше 38 о С, озноб, головная боль, слабость, снижение аппетита, тошнота, рвота, боли в животе. Отмечается чувство тяжести в правом подреберье. Наблюдаются запоры, иногда - поносы.
При обследовании органов пищеварения находят увеличение печени и чувствительность при её пальпации в правом подреберье.
В периферической крови у большой части пациентов наблюдается небольшая лейкопения, без изменений в лейкоцитарной формуле и показателей СОЭ.
Активность аминотрансфераз (АлАТ и АсАТ) в сыворотке крови повышается за 5-7 дней до появления желтухи, нарушения пигментного обмена наступают лишь в конце преджелтушного периода. К концу преджелтушного периода моча становится концентрированной, темной (цвета пива). Наблюдается обесцвечивание кала, появляется субиктеричность склер.
Желтушный период. Желтуха нарастает быстро, как правило, достигая максимума в течение недели. С появлением желтухи ряд симптомов преджелтушного периода ослабевает и у значительной части больных исчезает, при этом дольше всего сохраняется слабость и снижение аппетита. Иногда сохраняется чувство тяжести в правом подреберье.
При пальпации живота отмечается умеренная болезненность в правом подреберье. Размеры печени увеличены, она имеет гладкую поверхность, несколько уплотненную консистенцию. Чем младше пациент, тем чаще наблюдается увеличение селезенки.
В периферической крови обнаруживается лейкопения, реже - нормальное количество лейкоцитов, характерен относительный лимфоцитоз, иногда - моноцитоз.
Характерно выявление всех основных синдромов поражения печени: цитолиза, внутрипеченочного холестаза, поликлональной гаммапатии (мезенхимально-воспалительного синдрома) и недостаточности белково-синтетической функции печени (при тяжелых формах заболевания).
Гипербилирубинемия обычно умеренна и непродолжительна. На 2-й неделе желтухи, как правило, отмечается снижение уровня билирубина с последующей его полной нормализацией. Закономерно повышение активности аланинаминотрансферазы (АлАТ) и аспартатаминотранферазы (АсАТ), коэффициент де Ритиса (отношение показателя АсАТ к АлАТ), как правило, меньше 1,0. Желтушный период длится обычно 7-15 дней. Заболевание редко пролонгируется более 1 месяца. Тяжелые формы встречаются редко. Описано течение ГА по типу фульминантного гепатита и развитие апластической анемии.
При ГА принято выделять легкие, среднетяжелые и тяжелые формы заболевания. Наиболее существенным клиническим показателем тяжести течения болезни является выраженность интоксикации. Уровень билирубина до 85 мкмоль/л характеризует легкое течение заболевания, от 86 до 170 мкмоль/л - среднетяжелое, а свыше 170 мкмоль/л - тяжелое. Показатели цитолиза слабо коррелируют с тяжестью заболевания. Для объективной оценки тяжести течения заболевания следует оценивать как уровень билирубина, так и выраженность интоксикации.
Период реконвалесценции характеризуется быстрым исчезновением клинических и биохимических признаков гепатита. Из функциональных печеночных проб быстрее других нормализуется содержание билирубина в сыворотке крови, несколько позднее - показатели АлАТ и АсАТ. В некоторых случаях, однако, отмечается затяжная реконвалесценция с повышением активности АлАТ в течение 1-2 месяцев после исчезновения всех клинических симптомов. Хронические формы не развиваются.
Безжелтушный вариант имеет те же клинические (за исключением желтухи) и биохимические (за исключением синдрома внутрипеченочного холестаза) признаки, с меньшей выраженностью интоксикации и меньшей продолжительностью заболевания.
Субклинический и инаппаратный варианты. В эпидемических очагах пациенты с данной формой инфекции составляют в среднем 30% от общего числа инфицированных. В детских дошкольных коллективах до 70% случаев. Существует обратнопропорциональная зависимость: чем младше пациент, тем чаще развиваются безжелтушные формы заболевания. Так в возрасте до 2-х лет - 90% заболеваний безжелтушными формами
Субклинический вариант характеризуется полным отсутствием клинических проявлений при наличии синдромов цитолиза и гаммапатии. Инаппарантный вариант характеризуется отсутствием как клинических проявлений, так и биохимических синдромов поражения печени. Диагноз можно установить только при специальном лабораторном обследовании с выявлением маркеров ГА.
ЛАБОРАТОРНЫЕ СПЕЦИФИЧЕСКИЕ МАРКЕРЫ.
Для раннего выявления источников инфекции используется определение антигена ГА (АgВГА) в фекалиях. Анти-ВГА IgМ появляются в крови еще в фазу инкубации, за 3-5 дней до появления первых симптомов и продолжают циркулировать на всем протяжении клинического периода болезни и позже в течение 4-6 месяцев.
Обнаружение анти-ВГА IgМ однозначно свидетельствует об инфицировании вирусом ГА и используется для диагностики заболевания и выявления источников инфекции в очагах.
Анти ВГА класса IgG появляются в крови больных с 3-4 недели заболевания и свидетельствуют об окончании активного инфекционного процесса, титр их нарастает и достигает максимума через 3-6 месяцев. Анти-ВГА IgG длительно (в течение многих лет).
Гепатит А
ирусный гепатит А (ГА) - острая энтеровирусная циклическая инфекция спреимущественнофекально-оральным механизмом заражения.
Этиология. Возбудитель - вирус гепатита А (ВГА) - РНК-содержащий энтеровирус 72-го типа, относящийся к семейству пикорнавирусов. ВГА устойчив к окружающей среде: при комнатной температуре может сохраняться в течение нескольких недель, а при 4 °"С - несколько месяцев. Однако его можно инактивировать кипячением в течение 5 мин, автоклавированием, ультрафиолетовым облучением или воздействием дезинфектантов.
Эпидемиология. Источником инфекции чаще всего являются больные с бессимптомной (субклинический и инаппарантный варианты) формой, безжелтушным и стертым течением инфекции или больные, находящиеся в инкубационном, продромальном периодах и начальной фазе периода разгара болезни, в фекалиях которых обнаруживаются ВГА (HAV).
Ведущий механизм заражения ГА - фекально-оральный, реализуемый водным, пищевым и контактно-бытовым путями передачи. Существует возможность реализации данного механизма и половым путем при орально-генитальных и, особенно, орально-анальных контактах. Удельный вес гем опер кутанного механизма, реализуемого, какправило, при парентеральном инфицировании, составляет около 5%. Наиболее часто это происходит при повторном применении игл и шприцев внутривенными пользователями наркотиков.
Восприимчивость к ГА всеобщая. Наиболее часто заболевание регистрируют у детей старше 1 года (особенно в возрасте 3-12 лет и в организованных коллективах) и у молодых лиц (20-29 лет). Дети до 1 года малочувствительны к заражению ввиду сохранения у них пассивного иммунитета, переданного от матери. У людей в возрасте старше 30-35 лет вырабатывается активный иммунитет, подтверждаемый обнаружением антител к вирусу (IgG анти-HAV) в сыворотке крови 60-97% доноров.
ГА свойственно сезонное повышение заболеваемости в летне-осенний период. Наряду с сезонным отмечается и циклическое повышение заболеваемости ГА через 3-5, 7-20 лет, что связано с изменением иммунной структуры популяции хозяев вируса.
Патогенез. ГА - острая циклическая инфекция, характеризующаяся четкой сменой периодов.
После заражения ВГА из кишечника проникает в кровь и далее в печень, где после фиксации к рецепторам гепатоцитов проникает внутриклеточно. На стадии первичной репликации отчетливых повреждений гепатоцитов не обнаруживается. Новые поколения вирусов выделяются в желчные канальцы и далее поступают в кишечник и выделяются с фекалиями во внешнюю среду. Часть вирусной массы проникает в кровь, обусловливая развитие интоксикационной симптоматики продромального периода. Повреждения гепатоцитов, возникающие в ходе дальнейшего течения ГА, обусловлены не репликацией вируса, а иммуноопосредованным цитолизом. В периоде разгара ГА морфологическое исследование позволяет выявить воспалительные и некробиотические процессы, происходящие преимущественно в перипортальной зоне печеночных долек и портальных трактах. Эти процессы лежат в основе развития трех основных клинико-биохимических синдромов: цитолитического, мезенхимально-воспалительного и холестатического.
К лабораторным признакам цитолитическсео синдрома относят повышение активности ферментов АлАТ и АсАТ (аланинамино- и аспартатаминотрансферазы), уровня железа в сыворотке крови, снижение синтеза альбумина, протромбина и других факторов свертывания крови, эфиров холестерина. Начальным этапом цитолитического синдрома является повышение проницаемости мембраны гепатоцитов. Это обусловливает выход в кровь прежде всего АлАТ - фермента, находящегося в цитоплазме печеночной клетки. Повышение активности АлАТ - ранний и надежный индикатор повреждения гепатоцита. Однако следует подчеркнуть, что цитолитический синдром развивается в ответ на любое повреждающее воздействие (токсины вирусов, микробов, гипоксия, медикаменты, яды и пр.), поэтому повышение активности АлАТ характерно не только для вирусных гепатитов.
Мезенхимально-воспалительный синдром характеризуется повышением уровня р и у-глобулинов всех классов, изменением коллоидных проб (снижение сулемового титра и повышение показателя тимоловой пробы). Холестатический синдром проявляется повышением в крови уровня связанного билирубина, желчных кислот, холестерина, меди, активности щелочной фосфатазы, а также билирубинурией, уменьшением (исчезновением) уробилиновыхтел в моче.
Благодаря действию комплексных иммунных механизмов (усиление интерферонопродукции, активизация естественных киллеров, антител оп редукция и активность антител озави си мых киллеров) репликация вируса прекращается, и происходит его элиминация из организма человека. Для ГА не характерны ни длительное присутствие вируса в организме, ни развитие хронической формы болезни. Однако иногда течение заболевания может быть модифицировано в случаях коинфекции или суперинфекции другими гепатотропными вирусами. У лиц с генетической предрасположенностью возможно развитие хронического активного аутоиммунного гепатита 1-го типа.
Клиника. ГА характеризуется полиморфизмом клинических проявлений. Различают следующие формы ГА. По степени выраженности клинических проявлений: бессимптомная (субклиническая и инаппарантная) и манифестная (желтушная, безжелтушная, стертая). По длительности течения: острая и затяжная. По степени тяжести течения: легкая, средней тяжести и тяжелая.
Осложнения: рецидивы, обострения, поражения желчевыводящих п утей.
Исходы: выздоровление без остаточных явлений, с остаточными явлениями - постгепатитный синдром, затяжная реконвалесценция, поражение желчных путей (дискинезия, холецистит).
Большое значение имеет повышение санитарной культуры населения. За лицами, находившимися в контакте с больным ГА, устанавливают наблюдение сроком 35 дней, вовремя которого проводят систематическое (1 раз в нед.) клиническое наблюдение с целью раннего выявления первых признаков болезни и биохимическое обследование - определение активности АлАТ.
Контактным детям и беременным по эп ид показаниям вводят донорский иммуноглобулин в дозах, соответствующих возрасту (от 1 года до 6 лет - 0,75 мл, 7-10 лет- 1,5мл, старше 10 лет-3 мл). Для иммунопрофилактики желательно иметь специфический иммуноглобулин с высоким титром антител к ВГА (0,05 мл/кг массы тела, внутримышечно).
Существующие инактивированные моновакцины "ГЕПАИН-ВАК", "HAVRIX" и дивакцины А/В предназначены для активной профилактики ГА прежде всего на территориях с высоким уровнем заболеваемости ГА.
Лабораторная диагностика заболеваний печени
Врач лабораторной диагностики
(заведующий клинико-
диагностической лабораторией)
Лавицкая Т.В.
Печень играет важную роль в обмене белков, углеводов, липидов. Клетки печени метаболизируют, детоксицируют и экскретируют экзо - и эндогенные вещества. Важной функцией печени является синтез белков плазмы. В печени также синтезируется желчные кислоты, необходимые для переваривания и всасывания жиров. Гликолиз, цикл Кребса, синтез и распад аминокислот, реакции окислительного фосфорилирования – все эти процессы представлены в гепатоцитах, богатых митохондриями. В печени представлены 2 основных типа клеток: гепатоциты или паренхиматозные клетки, составляющие около 60% всей клеточной массы, и Купферовы клетки, входящие в состав ретикуло-эндотелиальной системы и составляющие 30% от всех клеток печени.
Функции печени
- Обмен углеводов.
- Обмен аминокислот и белков.
- Обмен липидов.
- Обмен желчных кислот.
- Конъюгация и детоксикация.
Лабораторные тесты диагностики заболеваний печени
Под тестами оценки функций печени обычно подразумеваются измерения компонентов крови, свидетельствующих о наличии и типе поражения печени. В повседневной клинической практике для этого используется определение уровня билирубина, активности ферментов (трансаминаз и щелочной фосфатазы) в образцах сыворотки. Определение концентрации сывороточного альбумина также может быть одним из показателей заболеваний печени. Эти биохимические определения могут помочь в дифференциации следующих состояний:
- Обструкция билиарного тракта.
- Острое гепатоцеллюлярное повреждение.
- Хронические заболевания печени.
Концентрация общего билирубина сыворотки и активность сывороточной фосфатазы свидетельствует о холестазе, блокаде оттока желчи.
Концентрация альбумина сыворотки является одним из существенных показателей синтетической способности печени, хотя на уровень альбумина влияют и многие другие факторы.
Клинические и биохимические синдромы
Болезни печени сопровождаются рядом лабораторных синдромов. При анализе результатов биохимического исследования у больных с заболеваниями печени целесообразно выделять четыре лабораторных синдрома, каждый из которых в известной степени соответствует определенным морфологическим и функциональным изменениям в органе: цитолитический синдром, мезенхимально-воспалительный синдром, холестатический синдром (синдомхолестаза), синдром малой печеночно-клеточной недостаточности, Обычно в каждом конкретном случае заболевания имеет место сочетание нескольких биохимических синдромов.
Синдром нарушения целостности гепатоцитов (синдром цитолиза или цитолитический синдром). Характеризуется повышением в плазме крови активности индикаторных ферментов – АсАТ (аспартатаминотрансферазы), АлАТ (аланинаминотрансферазы), ЛДГ (лактатдегидрогеназы) и ее изоферментов – ЛДГ4 и ЛДГ3; специфических печеночных ферментов: фруктозо-1-фосфатальдолазы, сорбитдегидрогеназы, а также концентрации ферритина, сывороточного железа, витамина В12 и билирубина главным образом за счет повышения прямой фракции.
В оценке степени выраженности патологического процесса основное значение придается активности АлАТ и АсАТ. Повышение их уровня в сыворотке крови менее чем в 5 раз по сравнению с верхней границей нормы рассматривается как умеренная, от 5 до 10 раз – как средняя степень и свыше 10 раз – как высокая степень выраженности.
Морфологической основой этого синдрома являются гидропическая и ацидофильная дистрофия и некроз гепатоцитов с повреждением и повышением проницаемости клеточных мембран.
Синдром холестаза (экскреторно-билиарный синдром, холестатический синдром – нарушение экскреторной функции печени). Сопровождается повышением уровня в сыворотке крови ЩФ (щелочная фосфатаза), ЛАП (лейцинаминопептидаза), ГГТФ, холестерина, Р-липопротеинов, конъюгированной фракции билирубина, желчных кислот, фосфолипидов, снижается экскреция бромсульфалеина (вофавердина) и радиофармакологических препаратов. Морфологической основой внутриклеточного холестаза являются ультраструктурные изменения гепатоцита – гиперплазия гладкой цитоплазматической сети, изменения билиарного полюса гепатоцита, накопление компонентов желчи в гепатоците, которые нередко сочетаются с цитолизом гепатоцитов. При внутрипеченочномхолестазе выявляют накопление желчи в желчных ходах, а при внепеченочном – расширение междольковых желчных протоков.
Синдром печеночно-клеточной недостаточности (синдром синтетической недостаточности). Проявляется уменьшением содержания в сыворотке крови общего белка и особенно альбумина, трансферрина, холестерина, II, V, VII факторов свертывания крови, холинэстеразы, альфа-липопротеинов, но в то же время повышением билирубина за счет неконъюгированной фракции. Морфологическим субстратом синдрома являются выраженные дистрофические изменения гепатоцитов и/или значительное уменьшение функционирующей паренхимы печени вследствие ее некротических изменений.
Нарушенная функция гепатоцитов может приводить к нарушению синтеза альбумина, что наблюдается при хронических заболеваниях печени. Наиболее выраженные гипоальбуминемии выявляются при портальном циррозе, жировой дистрофии печени.
Мезенхимально-воспалительный синдром. Характеризуется гипергамма-глобулинемией, повышением показателей белково-осадочных проб, увеличением СОЭ, появлением в крови продуктов деградации соединительной ткани (С-реактивный белок, серомукоид и др.). Наблюдаются изменения показателей клеточных и гуморальных иммунных реакций: появляются антитела к субклеточным фракциям гепатоцита, ревматоидный фактор, антимитохондриальные и антиядерные антитела, изменения количества и функциональной активности Т - и В-лимфоцитов, а также повышение уровня иммуноглобулинов.
При морфологических исследованиях печени характерна активация и пролиферация лимфоидных и ретикулогистиоцитарных клеток, усиление фиброгенеза, формирование активных септ с некрозами гепатоцитов, внутрипеченочная миграция лейкоцитов, васкулиты.
Синдром цитолиза
(цитолитический синдром или синдром нарушения целостности гепатоцитов)
↑ АсАТ, АлАТ, ЛДГ и ее изоферментов – ЛДГ4 и ЛДГ3, фруктозо-1-фосфатальдолазы, сорбит-дегидрогеназы, а концентрации ферритина, сывороточного железа, витамина В12 и билирубина за счет повышения прямой фракции
Синдром холестаза
(экскреторно-билиарный синдром, холестатический синдром
↑ ЩФ, ЛАП, ГГТФ, холестерина, Р-липопротеинов, конъюгированной фракции билирубина, желчных кислот, фосфолипидов
Синдром печеночно-клеточной недостаточности
(синдром синтетической недостаточности)
↓ общего белка (особенно альбумина), трансферрина, холестерина, II, V, VII факторов свертывания крови, холинэстеразы, альфа-липопротеинов
↑ билирубина за счет неконъюгированной фракции
Мезенхимально-воспалительный синдром
↑ СОЭ, появление в крови С-реактивного белка, ревматоидного фактора, антител к субклеточным фракциям гепатоцита, антимитохондриальных и антиядерных антител, изменение количества и функциональной активности Т - и В-лимфоцитов, повышение уровня иммуноглобулинов.
Энзимодиагностика заболеваний печени
Печень продуцирует большое число ферментов, поступающих непосредственно в кровь. При поражениях печени количество одних ферментов в сыворотке крови понижается, а других – повышается.
Ферменты, которые обнаруживаются в норме в плазме или сыворотке крови, условно можно разделить на 3 группы.
Секреторные ферменты, синтезируясь в печени, в норме выделяются в плазму крови, где играют определенную физиологическую роль, например ферменты, участвующие в процессе свертывания крови (протромбиназа), холинэстераза. При поражении печени их синтез снижается, и активность этих ферментов падает.
Индикаторные ферменты попадают в кровь из тканей, где они выполняют определенные внутриклеточные функции. Одни из них находятся в цитозоле клеток (ЛДГ, АлАТ, АсАТ), другие – в митохондриях (ГДГ, АсАТ) и т. д.
При поражении печени ферменты из клеток вымываются в кровь, и активность их возрастает. Наибольшее диагностическое значение имеет определение активности АлАТ и АсАТ. Активность трансаминаз в сыворотке крови: АсАТ – 5-40 Е/л, АлАТ – 5-43 Е/л. При остром паренхиматозном гепатите АлАТ увеличивается в 20-30, а иногда в 100 раз и более. Несколько меньше повышается активность АсАТ.
Экскреторные ферменты синтезируются главным образом в печени (щелочная фосфатаза). В физиологических условиях эти ферменты в основном выделяются с желчью. При многих патологических процессах выделение экскреторных ферментов с желчью нарушается, а активность их в плазме крови повышается.
Щелочная фосфатаза.
Увеличение активности щелочной фосфатазы (ЩФ) при заболеваниях печени является результатом увеличенного синтеза фермента клетками, расположенными в желчных канальцах, обычно в ответ на холестаз, который может быть интра - и внепеченочным. Холестаз, даже непродолжительный, приводит к увеличенной активности фермента, по крайней мере, вдвое превышающий нормальный уровень. Высокая активность ЩФ может также наблюдаться при инфильтративных заболеваниях печени (например, опухолях). Это также характерно для цирроза.
Печень не является единственным источником активности ЩФ. Умеренные количества ЩФ представлены в костях, тонком кишечнике, плаценте, почках.
Лактатдегидрогеназа.
Уровень ЛДГ часто возрастает при гепатоцеллюлярной дисфункции, хотя на практике определение активности этого фермента редко используют в диагностике заболеваний печени из-за низкой специфичности показателя (фермент широко распространен в организме).
γ-глутамилтранспептидаза.
γ-глутамилтранспептидаза (ГГТП) – это микросомальный фермент, широко представленный в тканях, особенно таких, как печень и почечные канальцы.
Активность γ-глутамилтранспептидазы в плазме резко повышается (иногда более, чем в 50 раз) при холестазе и является показателем печеночной недостаточности. Увеличение активности ГГТП наблюдается также у лиц, употребляющих алкоголь, даже в отсутствии явной патологии печени. При остром поражении печени изменение активности ГГТП параллельны изменениям активности трансаминаз.
Глутаматдегидрогеназа катализирует превращение глутаминовой кислоты в альфа-кетоглутаровую и аммиак; фермент сосредоточен в митохондриях клеток, преимущественно в гепатоцитах. Он также обнаружен в незначительном количестве в нервной ткани, скелетных мышцах, миокарде и молочной железе.
Глутаматдегидрогеназа - один из органоспецифических ферментов, определяется в сыворотке крови при заболеваниях печени.
Поскольку фермент является митохондриальным, то степень повышения его активности отражает глубину цитолиза при заболеваниях печени, по её уровню можно судить о тяжести патологического процесса.
Сорбитолдегидрогеназа – органоспецифический фермент печени, катализирующий обратимое превращение сорбитола во фруктозу с участием НАД в качестве кофермента. Фермент локализован в цитоплазме гепатоцитов. Сывороточная активность энзима повышается при вирусных гепатитах. Как правило повышение активности СДГ наблюдается в дожелтушный период вирусного гепатита, предшествует увеличению активности других (ферментов, отражающих поражение печени. Однако высокие цифры активности СДГ выявляются в разгар болезни, иными словами, тест уступает по чувствительности другим органоспецифический ферментам и определению активности аминотрансфераз. Кроме того, активность СДГ нормализуется быстрее, чем активность аминотрансфераз, что также является недостатком теста. Другие заболевания печени (токсические гепатиты, циррозы, гипоксические поражения печени) сопровождаются незначительным увеличением активности энзима.
Читайте также:
